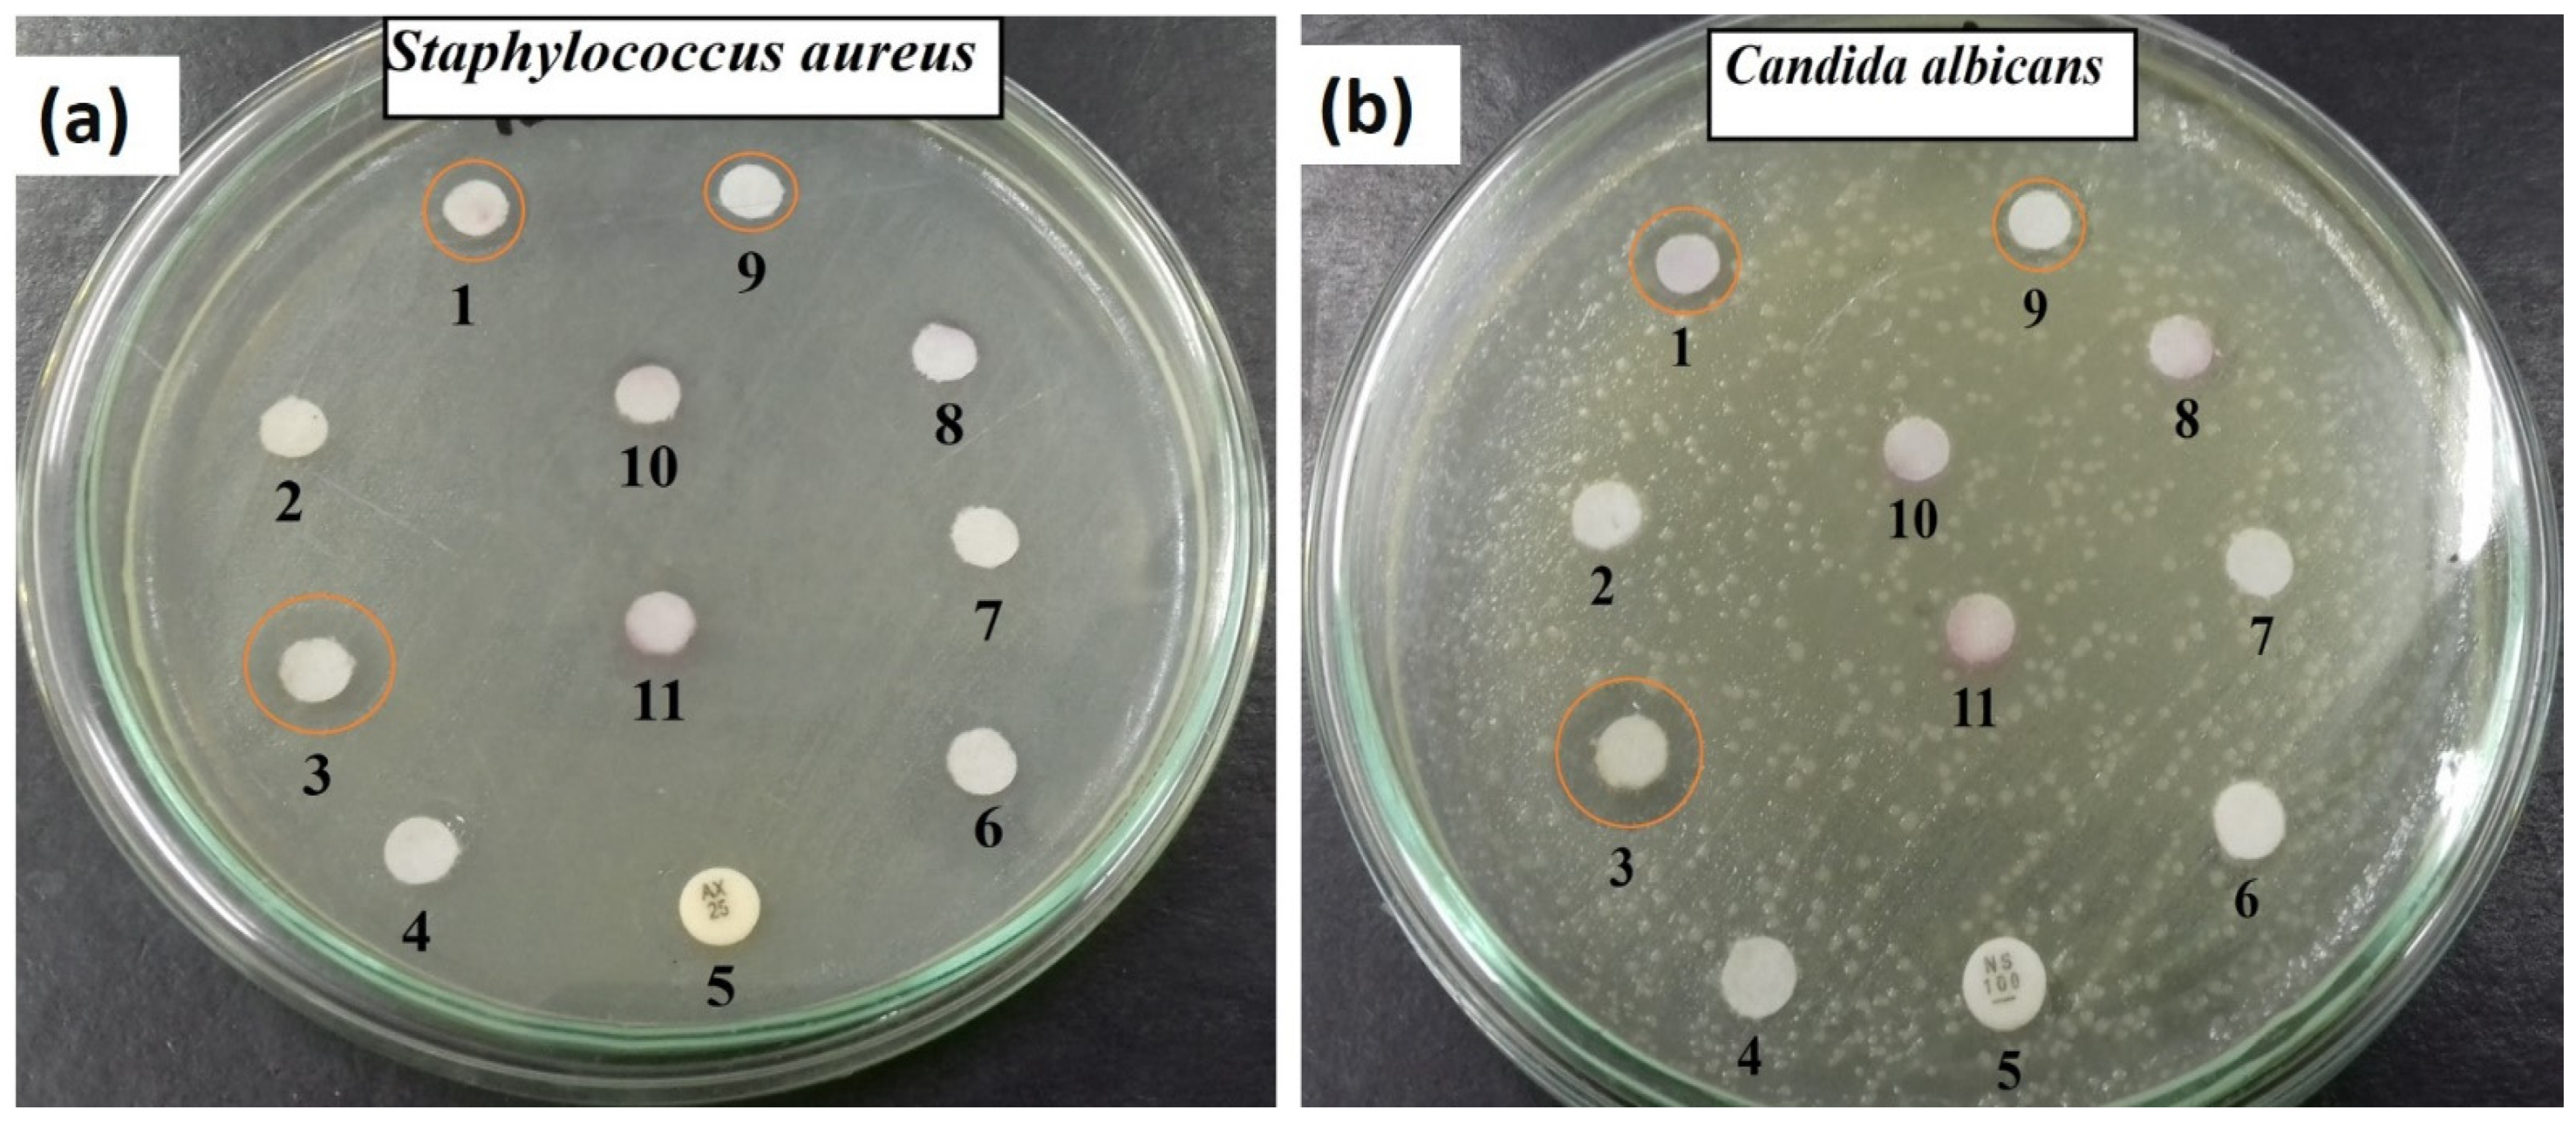
Ijms 22 10171 g007 550

Influence of Ce3+ Substitution on Antimicrobial and Antibiofilm Properties of ZnCexFe2−xO4 Nanoparticles (X = 0.0, 0.02, 0.04, 0.06, and 0.08) Conjugated with Ebselen and Its Role Subsidised with γ-Radiation in Mitigating Human TNBC and Colorectal Adenocarcinoma Proliferation In Vitro
Abstract
:1. Introduction
2. Results and Discussion
2.1. Structural Studies
2.2. Antimicrobial Potential
2.3. Antibiofilm Activity of ZnCexFe2−xO4; X = 0.06
2.4. Reaction Mechanism Determination Using SEM Analysis
2.5. Determination of Protein Leakage from Bacterial Cell Membranes
2.6. Antitumour Activity of Eb-ZFO and Eb-ZnCexFe2−xO4; X = 0.06 Nanocomposites with or without γ-Radiation
2.6.1. Screening of the Cytotoxic Profile of Different Concentrations of Eb and ZnCexFe2−xO4 Nanocomposites on Human Breast Cancer (MDA-MB-231; Triple-Negative Basal B Subtype) and Colon Cancer (HT-29; Colorectal Adenocarcinoma)
2.6.2. ROS Status and Signaling Molecules ERK1/2, JNK and NRF-2 in MDA-MB-231 and HT-29 Cells
MDA-MB-231 Cell Line
HT-29 Cell Line
2.6.3. Inflammatory Status and Crosstalk of Signalling Pathways TNF-α/NF-κB, INF-γ/STAT-1, and IL-4/STAT-6 in MDA-MB-231 and HT-29 Cell
MDA-MB-231 Cell Line
HT-29 Cell Line
2.6.4. Assessment of Autophagy and Apoptosis-Related Proteins in MDA-MB-231 and HT-29 Cells
MDA-MB-231 Cell Line
HT-29 Cell Line
2.6.5. Flow Cytometric Analysis of Cell Cycle inMDA-MB-231 and HT-29 Cells
MDA-MB-231 Cell Line
HT-29 Cell Lines
2.6.6. Detection of Apoptosis in MDA-MB-231 and HT-29 Cells Lines by Flow Cytometry
MDA-MB-231 Cell Lines
HT-29 Cell Lines
3. Materials and Methods
3.1. Synthesis of ZnCexFe2−xO4 Nanoferrites
3.2. Characterisation of the Nanoferrites
3.3. Antimicrobial Activities of ZnCexFe2−xO4 Nanoparticles and Ebselen
3.4. Antibiofilm Activities of ZnCexFe2−xO4 Nanoparticles (X = 0.0 and 0.06)
3.5. Reaction Mechanism Using SEM Analysis
3.6. Effect of the Synthesised Nanocomposites on Protein Leakage from Bacterial Cell Membranes
3.7. Cell Lines, Treatment, and Reagents
3.8. Culture Media
3.9. Subculture of Cell Lines
3.10. Sulforhodamine B (SRB) Assay
3.11. Irradiation
3.12. Culture Models and Experimental Protocol
- The MDA-MB-231 cell line was divided into four groups. The MDA group: untreated MDA-MB-231 cells line served as control; the MDA + Eb-ZFO group: MDA-MB-231 cells treated with Ebselen (Eb) and ZnFe2O4 nanoparticles (ZFO); the MDA + IR group: MDA-MB-231 cells exposed to ionising radiation; and the MDA + Eb-ZFO + IR group: MDA-MB-231 cells treated with Eb-ZFO and exposed to IR.
- The HT-29 cell line was divided into four groups. The HT-29 group: untreated HT-29 cells served as a control; the HT-29 + Eb-ZCFO group: HT-29 cells treated with Eb and ZnCe0.06Fe1.94O4 nanoparticles (ZCFO); the HT-29 + IR group: HT-29 cells exposed to ionising radiation; and the HT-29 + Eb-ZCFO + IR group: HT-29 cells treated with Eb-ZCFO and exposed to IR.
3.13. Cell-Cycle Analysis and Apoptosis Detection Using Flow Cytometry
3.14. Determination of Intracellular Hydrogen Peroxide (H2O2)
3.15. Quantification of Pro- and Anti-Inflammatory Cytokines, Pro- and Anti-Apoptotic, and Oxidative Stress Markers by ELISA
3.16. Western Blot Analysis
3.17. Statistics
4. Conclusions
Supplementary Materials
Author Contributions
Funding
Institutional Review Board Statement
Informed Consent Statement
Data Availability Statement
Acknowledgments
Conflicts of Interest
References
- Supriya, S.; Kumar, S.; Kar, M. Electrical Properties and Dipole Relaxation Behavior of Zinc-Substituted Cobalt Ferrite. J. Electron. Mater. 2017, 46, 6884–6894. [Google Scholar] [CrossRef]
- Rani, R.; Kumar, G.; Batoo, K.M.; Singh, M. Influence of temperature on the electric, dielectric and AC conductivity properties of nano-crystalline zinc substituted cobalt ferrite synthesized by solution combustion technique. Appl. Phys. A 2014, 115, 1401–1407. [Google Scholar] [CrossRef]
- Sinfrônio, F.; Santana, P.; Coelho, S.; Silva, F.; de Menezes, A.; Sharma, S. Magnetic and structural properties of cobalt-and zinc-substituted nickel ferrite synthesized by microwave-assisted hydrothermal method. J. Electron. Mater. 2017, 46, 1145–1154. [Google Scholar] [CrossRef]
- Rani, B.J.; Mageswari, R.; Ravi, G.; Ganesh, V.; Yuvakkumar, R. Physico-chemical properties of pure and zinc incorporated cobalt nickel mixed ferrite (ZnxCo0.005−xNi0.005Fe2O4, where x = 0, 0.002, 0.004 M) nanoparticles. J. Mater. Sci. Mater. Electron. 2017, 28, 16450–16458. [Google Scholar] [CrossRef]
- Sodaee, T.; Ghasemi, A.; Razavi, R.S. Cation distribution and microwave absorptive behavior of gadolinium substituted cobalt ferrite ceramics. J. Alloy. Compd. 2017, 706, 133–146. [Google Scholar] [CrossRef]
- Vaithyanathan, V.; Ugendar, K.; Arout Chelvane, J.; Kamala Bharathi, K.; Inbanathan, S.S.R. Structural and magnetic properties of Sn and Ti doped Co ferrite. J. Magn. Magn. Mater. 2015, 382, 88–92. [Google Scholar] [CrossRef]
- Pawar, R.A.; Patange, S.M.; Tamboli, Q.Y.; Ramanathan, V.; Shirsath, S.E. Spectroscopic, elastic and dielectric properties of Ho3+ substituted Co-Zn ferrites synthesized by sol-gel method. Ceram. Int. 2016, 42, 16096–16102. [Google Scholar] [CrossRef]
- Panda, R.; Muduli, R.; Jayarao, G.; Sanyal, D.; Behera, D. Effect of Cr3+ substitution on electric and magnetic properties of cobalt ferrite nanoparticles. J. Alloy. Compd. 2016, 669, 19–28. [Google Scholar] [CrossRef]
- Farid, H.M.T.; Ahmad, I.; Bhatti, K.; Ali, I.; Ramay, S.M.; Mahmood, A. The effect of praseodymium on Cobalt-Zinc spinel ferrites. Ceram. Int. 2017, 43, 7253–7260. [Google Scholar] [CrossRef]
- Ashour, A.H.; El-Batal, A.I.; Maksoud, M.I.A.A.; El-Sayyad, G.S.; Labib, S.; Abdeltwab, E.; El-Okr, M.M. Antimicrobial activity of metal-substituted cobalt ferrite nanoparticles synthesized by sol–gel technique. Particuology 2018, 40, 141–151. [Google Scholar] [CrossRef]
- Abdel Maksoud, M.I.A.; El-Sayyad, G.S.; Ashour, A.H.; El-Batal, A.I.; Abd-Elmonem, M.S.; Hendawy, H.A.M.; Abdel-Khalek, E.K.; Labib, S.; Abdeltwab, E.; El-Okr, M.M. Synthesis and characterization of metals-substituted cobalt ferrite [MxCo(1-x)Fe2O4; (M = Zn, Cu and Mn; x = 0 and 0.5)] nanoparticles as antimicrobial agents and sensors for Anagrelide determination in biological samples. Mater. Sci. Eng. C 2018, 92, 644–656. [Google Scholar] [CrossRef] [PubMed]
- Maksoud, M.I.A.A.; El-Sayyad, G.S.; Ashour, A.H.; El-Batal, A.I.; Elsayed, M.A.; Gobara, M.; El-Khawaga, A.M.; Abdel-Khalek, E.K.; El-Okr, M.M. Antibacterial, antibiofilm, and photocatalytic activities of metals-substituted spinel cobalt ferrite nanoparticles. Microb. Pathog. 2019, 127, 144–158. [Google Scholar] [CrossRef] [PubMed]
- Weissman, S.; Sebrow, J.; Gonzalez, H.H.; Weingarten, M.J.; Rosenblatt, S.; Mehta, T.I.; Thaker, R.; Krzyzak, M.; Saleem, S. Diagnosis of Primary Colorectal Carcinoma with Primary Breast Cancer: Associations or Connections? Cureus 2019, 11, e4287. [Google Scholar] [CrossRef] [PubMed] [Green Version]
- Casey, S.C.; Amedei, A.; Aquilano, K.; Azmi, A.S.; Benencia, F.; Bhakta, D.; Bilsland, A.E.; Boosani, C.S.; Chen, S.; Ciriolo, M.R. Cancer prevention and therapy through the modulation of the tumor microenvironment. In Seminars in Cancer Biology; Elsevier: Amsterdam, The Netherlands, 2015; pp. S199–S223. [Google Scholar]
- Wang, J.-S.; Wang, H.-J.; Qian, H.-L. Biological effects of radiation on cancer cells. Mil. Med. Res. 2018, 5, 1–10. [Google Scholar] [CrossRef]
- Lee, S.H.; Jun, B.-H. Silver nanoparticles: Synthesis and application for nanomedicine. Int. J. Mol. Sci. 2019, 20, 865. [Google Scholar] [CrossRef] [Green Version]
- Johnson, J.; Chow, Z.; Napier, D.; Lee, E.; Weiss, H.L.; Evers, B.M.; Rychahou, P. Targeting PI3K and AMPKα Signaling Alone or in Combination to Enhance Radiosensitivity of Triple Negative Breast Cancer. Cells 2020, 9, 1253. [Google Scholar] [CrossRef]
- Speers, C.W.; Chandler, B.; Zhao, S.; Liu, M.; Wilder-Romans, K.; Olsen, E.; Nyati, S.; Rae, J.M.; Hayes, D.F.; Spratt, D.E. Radiosensitization of androgen receptor (AR)-positive triple-negative breast cancer (TNBC) cells using seviteronel (SEVI). In A Selective CYP17 Lyase and AR Inhibitor; American Society of Clinical Oncology: Alexandria, VA, USA, 2017. [Google Scholar]
- Eriksson, P.; Tal, A.A.; Skallberg, A.; Brommesson, C.; Hu, Z.; Boyd, R.D.; Olovsson, W.; Fairley, N.; Abrikosov, I.A.; Zhang, X. Cerium oxide nanoparticles with antioxidant capabilities and gadolinium integration for MRI contrast enhancement. Sci. Rep. 2018, 8, 1–12. [Google Scholar]
- Kaczor-Keller, K.B.; Pawlik, A.; Scianowski, J.; Pacuła, A.; Obieziurska, M.; Marcheggiani, F.; Cirilli, I.; Tiano, L.; Antosiewicz, J. In vitro anti-prostate cancer activity of two ebselen analogues. Pharmaceuticals 2020, 13, 47. [Google Scholar] [CrossRef] [Green Version]
- Zhang, L.; Gu, F.; Chan, J.; Wang, A.; Langer, R.; Farokhzad, O. Clinical Pharmacol. Therapeutics 2008, 83, 761. [Google Scholar]
- Dhall, A.; Self, W. Cerium oxide nanoparticles: A brief review of their synthesis methods and biomedical applications. Antioxidants 2018, 7, 97. [Google Scholar] [CrossRef] [Green Version]
- Reyes-Rodríguez, P.Y.; Cortés-Hernández, D.A.; Escobedo-Bocardo, J.C.; Almanza-Robles, J.M.; Sánchez-Fuentes, H.J.; Jasso-Terán, A.; De León-Prado, L.E.; Méndez-Nonell, J.; Hurtado-López, G.F. Structural and magnetic properties of Mg-Zn ferrites (Mg1−xZnxFe2O4) prepared by sol-gel method. J. Magn. Magn. Mater. 2017, 427, 268–271. [Google Scholar] [CrossRef]
- Ghodake, U.; Kambale, R.C.; Suryavanshi, S. Effect of Mn2+ substitution on structural, electrical transport and dielectric properties of Mg-Zn ferrites. Ceram. Int. 2017, 43, 1129–1134. [Google Scholar] [CrossRef]
- Alshahrani, B.; ElSaeedy, H.I.; Fares, S.; Korna, A.H.; Yakout, H.A.; Maksoud, M.I.A.A.; Fahim, R.A.; Gobara, M.; Ashour, A.H. The effect of Ce3+ doping on structural, optical, ferromagnetic resonance, and magnetic properties of ZnFe2O4 nanoparticles. J. Mater. Sci. Mater. Electron. 2020. [Google Scholar] [CrossRef]
- Murugesan, C.; Chandrasekaran, G. Impact of Gd3+ substitution on the structural, magnetic and electrical properties of cobalt ferrite nanoparticles. RSC Adv. 2015, 5, 73714–73725. [Google Scholar] [CrossRef]
- Yadav, R.S.; Havlica, J.; Masilko, J.; Kalina, L.; Wasserbauer, J.; Hajdúchová, M.; Enev, V.; Kuřitka, I.; Kožáková, Z. Impact of Nd3+ in CoFe2O4 spinel ferrite nanoparticles on cation distribution, structural and magnetic properties. J. Magn. Magn. Mater. 2016, 399, 109–117. [Google Scholar] [CrossRef]
- Abbas, M.K.; Khan, M.A.; Mushtaq, F.; Warsi, M.F.; Sher, M.; Shakir, I.; Aboud, M.F.A. Impact of Dy on structural, dielectric and magnetic properties of Li-Tb-nanoferrites synthesized by micro-emulsion method. Ceram. Int. 2017, 43, 5524–5533. [Google Scholar] [CrossRef]
- Bahhar, S.; Lemziouka, H.; Boutahar, A.; Bioud, H.; Lassri, H.; Hlil, E. Influence of La3+ site substitution on the structural, magnetic and magnetocaloric properties of ZnFe2−xLaxO4 (x = 0.00, 0.001, 0.005 and 0.01) spinel zinc ferrites. Chem. Phys. Lett. 2019, 716, 186–191. [Google Scholar] [CrossRef]
- Amer, M.; Matsuda, A.; Kawamura, G.; El-Shater, R.; Meaz, T.; Fakhry, F. Characterization and structural and magnetic studies of as-synthesized Fe2+CrxFe(2−x)O4 nanoparticles. J. Magn. Magn. Mater. 2017, 439, 373–383. [Google Scholar] [CrossRef]
- Amer, M.; Meaz, T.; Mostafa, A.; El-Ghazally, H. Structural and physical properties of the nano-crystalline Al-substituted Cr–Cu ferrite. J. Magn. Magn. Mater. 2013, 343, 286–292. [Google Scholar] [CrossRef]
- Kadam, R.H.; Alone, S.T.; Mane, M.L.; Biradar, A.R.; Shirsath, S.E. Phase evaluation of Li+ substituted CoFe2O4 nanoparticles, their characterizations and magnetic properties. J. Magn. Magn. Mater. 2014, 355, 70–75. [Google Scholar] [CrossRef]
- Kounsalye, J.S.; Humbe, A.V.; Chavan, A.R.; Jadhav, K. Rietveld, cation distribution and elastic investigations of nanocrystalline Li0.5+0.5xZrxFe2.5-1.5 xO4 synthesized via sol-gel route. Phys. B Condens. Matter 2018, 547, 64–71. [Google Scholar] [CrossRef]
- Maksoud, M.I.A.A.; El-ghandour, A.; El-Sayyad, G.S.; Awed, A.S.; Fahim, R.A.; Atta, M.M.; Ashour, A.H.; El-Batal, A.I.; Gobara, M.; Abdel-Khalek, E.K.; et al. Tunable structures of copper substituted cobalt nanoferrites with prospective electrical and magnetic applications. J. Mater. Sci. Mater. Electron. 2019, 30, 4908–4919. [Google Scholar] [CrossRef]
- Abdel Maksoud, M.I.A.; El-ghandour, A.; El-Sayyad, G.S.; Awed, A.S.; Ashour, A.H.; El-Batal, A.I.; Gobara, M.; Abdel-Khalek, E.K.; El-Okr, M.M. Incorporation of Mn2+ into cobalt ferrite via sol–gel method: Insights on induced changes in the structural, thermal, dielectric, and magnetic properties. J. Sol.-Gel. Sci. Technol. 2019, 90, 631–642. [Google Scholar] [CrossRef]
- Zipare, K.; Bandgar, S.; Shahane, G. Effect of Dy-substitution on structural and magnetic properties of MnZn ferrite nanoparticles. J. Rare Earths 2018, 36, 86–94. [Google Scholar] [CrossRef]
- Hafezi, M.; Rostami, M.; Hosseini, A.; Rahimi-Nasrabadi, M.; Fasihi-Ramandi, M.; Badiei, A.; Ahmadi, F. Cur-loaded ZnFe2O4@ mZnO@ N-GQDs biocompatible nano-carriers for smart and controlled targeted drug delivery with pH-triggered and ultrasound irradiation. J. Mol. Liq. 2021, 322, 114875. [Google Scholar] [CrossRef]
- Borthakur, S.; Saikia, L. ZnFe2O4@ g-C3N4 nanocomposites: An efficient catalyst for Fenton-like photodegradation of environmentally pollutant Rhodamine B. J. Environ. Chem. Eng. 2019, 7, 103035. [Google Scholar] [CrossRef]
- Xu, R.; Wu, C.; Xu, H. Particle size and zeta potential of carbon black in liquid media. Carbon 2007, 45, 2806–2809. [Google Scholar] [CrossRef]
- Soema, P.C.; Willems, G.-J.; Jiskoot, W.; Amorij, J.-P.; Kersten, G.F. Predicting the influence of liposomal lipid composition on liposome size, zeta potential and liposome-induced dendritic cell maturation using a design of experiments approach. Eur. J. Pharm. Biopharm. 2015, 94, 427–435. [Google Scholar] [CrossRef] [Green Version]
- Ravindran, S.; Williams, M.; Ward, R.; Gillies, G. Understanding how the properties of whey protein stabilized emulsions depend on pH, ionic strength and calcium concentration, by mapping environmental conditions to zeta potential. Food Hydrocoll. 2018, 79, 572–578. [Google Scholar] [CrossRef]
- Abdel Maksoud, M.I.A.; El-Sayyad, G.S.; El-Khawaga, A.M.; Abd Elkodous, M.; Abokhadra, A.; Elsayed, M.A.; Gobara, M.; Soliman, L.I.; El-Bahnasawy, H.H.; Ashour, A.H. Nanostructured Mg substituted Mn-Zn ferrites: A magnetic recyclable catalyst for outstanding photocatalytic and antimicrobial potentials. J. Hazard. Mater. 2020, 399, 123000. [Google Scholar] [CrossRef] [PubMed]
- Franks, K.; Kestens, V.; Braun, A.; Roebben, G.; Linsinger, T.P. Non-equivalence of different evaluation algorithms to derive mean particle size from dynamic light scattering data. J. Nanoparticle Res. 2019, 21, 1–10. [Google Scholar] [CrossRef] [Green Version]
- El-Sayyad, G.S.; El-Bastawisy, H.S.; Gobara, M.; El-Batal, A.I. Gentamicin-Assisted Mycogenic Selenium Nanoparticles Synthesized Under Gamma Irradiation for Robust Reluctance of Resistant Urinary Tract Infection-Causing Pathogens. Biol. Trace Elem. Res. 2020, 195, 323–342. [Google Scholar] [CrossRef] [PubMed]
- Wong, C.W.; Chan, Y.S.; Jeevanandam, J.; Pal, K.; Bechelany, M.; Abd Elkodous, M.; El-Sayyad, G.S. Response Surface Methodology Optimization of Mono-dispersed MgO Nanoparticles Fabricated by Ultrasonic-Assisted Sol–Gel Method for Outstanding Antimicrobial and Antibiofilm Activities. J. Clust. Sci. 2020, 31, 367–389. [Google Scholar] [CrossRef]
- El-Batal, A.I.; El-Sayyad, G.S.; Al-Hazmi, N.E.; Gobara, M. Antibiofilm and Antimicrobial Activities of Silver Boron Nanoparticles Synthesized by PVP Polymer and Gamma Rays Against Urinary Tract Pathogens. J. Clust. Sci. 2019, 30, 947–964. [Google Scholar] [CrossRef]
- Awed, A.S.; El-Sayyad, G.S.; El-ghandour, A.; Hameed, M.F.O.; Abdel Maksoud, M.I.A.; El-Batal, A.I.; Obayya, S.S.A. Unveiling Antimicrobial Activity of Metal Iodide (CuI, AgI, and PbI2) Nanoparticles: Towards Biomedical Surfaces Applications. J. Clust. Sci. 2021, 32, 1–16. [Google Scholar] [CrossRef]
- Abd Elkodous, M.; El-Sayyad, G.S.; Youssry, S.M.; Nada, H.G.; Gobara, M.; Elsayed, M.A.; El-Khawaga, A.M.; Kawamura, G.; Tan, W.K.; El-Batal, A.I. Carbon-dot-loaded CoxNi1−xFe2O4; x = 0.9/SiO2/TiO2 nanocomposite with enhanced photocatalytic and antimicrobial potential: An engineered nanocomposite for wastewater treatment. Sci. Rep. 2020, 10, 1–22. [Google Scholar]
- Abd Elkodous, M.; El-Sayyad, G.S.; Abdelrahman, I.Y.; El-Bastawisy, H.S.; Mosallam, F.M.; Nasser, H.A.; Gobara, M.; Baraka, A.; Elsayed, M.A.; El-Batal, A.I. Therapeutic and diagnostic potential of nanomaterials for enhanced biomedical applications. Colloids Surf. B Biointerfaces 2019, 180, 411–428. [Google Scholar] [CrossRef]
- El-Batal, A.I.; Nada, H.G.; El-Behery, R.R.; Gobara, M.; El-Sayyad, G.S. Nystatin-mediated bismuth oxide nano-drug synthesis using gamma rays for increasing the antimicrobial and antibiofilm activities against some pathogenic bacteria and Candida species. RSC Adv. 2020, 10, 9274–9289. [Google Scholar] [CrossRef] [Green Version]
- Pal, K.; Si, A.; El-Sayyad, G.S.; Elkodous, M.A.; Kumar, R.; El-Batal, A.I.; Kralj, S.; Thomas, S. Cutting edge development on graphene derivatives modified by liquid crystal and CdS/TiO2 hybrid matrix: Optoelectronics and biotechnological aspects. Crit. Rev. Solid State Mater. Sci. 2020, 1–65. [Google Scholar] [CrossRef]
- Karthik, K.; Dhanuskodi, S.; Gobinath, C.; Prabukumar, S.; Sivaramakrishnan, S. Fabrication of MgO nanostructures and its efficient photocatalytic, antibacterial and anticancer performance. J. Photochem. Photobiol. B Biol. 2019, 190, 8–20. [Google Scholar] [CrossRef]
- Ansari, M.A.; Khan, H.M.; Khan, A.A.; Cameotra, S.S.; Pal, R. Antibiofilm efficacy of silver nanoparticles against biofilm of extended spectrum β-lactamase isolates of Escherichia coli and Klebsiella pneumoniae. Appl. Nanosci. 2014, 4, 859–868. [Google Scholar] [CrossRef] [Green Version]
- Ashajyothi, C.; Harish, K.H.; Dubey, N.; Chandrakanth, R.K. Antibiofilm activity of biogenic copper and zinc oxide nanoparticles-antimicrobials collegiate against multiple drug resistant bacteria: A nanoscale approach. J. Nanostructure Chem. 2016, 6, 329–341. [Google Scholar] [CrossRef] [Green Version]
- Bradford, N. A rapid and sensitive method for the quantitation microgram quantities of a protein isolated from red cell membranes. Anal. Biochem. 1976, 72, e254. [Google Scholar] [CrossRef]
- Rajesh, S.; Dharanishanthi, V.; Kanna, A.V. Antibacterial mechanism of biogenic silver nanoparticles of Lactobacillus acidophilus. J. Exp. Nanosci. 2015, 10, 1143–1152. [Google Scholar] [CrossRef]
- Azam, Z.; Ayaz, A.; Younas, M.; Qureshi, Z.; Arshad, B.; Zaman, W.; Ullah, F.; Nasar, M.Q.; Bahadur, S.; Irfan, M.M. Microbial synthesized cadmium oxide nanoparticles induce oxidative stress and protein leakage in bacterial cells. Microb. Pathog. 2020, 144, 104188. [Google Scholar] [CrossRef] [PubMed]
- Paul, D.; Maiti, S.; Sethi, D.P.; Neogi, S. Bi-functional NiO-ZnO nanocomposite: Synthesis, characterization, antibacterial and photo assisted degradation study. Adv. Powder Technol. 2021, 32, 131–143. [Google Scholar] [CrossRef]
- El-Batal, A.I.; Mosallam, F.M.; El-Sayyad, G.S. Synthesis of Metallic Silver Nanoparticles by Fluconazole Drug and Gamma Rays to Inhibit the Growth of Multidrug-Resistant Microbes. J. Clust. Sci. 2018, 29, 1003–1015. [Google Scholar] [CrossRef]
- Liu, W.; Sun, W.; Borthwick, A.G.; Ni, J. Comparison on aggregation and sedimentation of titanium dioxide, titanate nanotubes and titanate nanotubes-TiO2: Influence of pH, ionic strength and natural organic matter. Colloids Surf. A Physicochem. Eng. Asp. 2013, 434, 319–328. [Google Scholar] [CrossRef]
- Taylor, E.N.; Webster, T.J. The use of superparamagnetic nanoparticles for prosthetic biofilm prevention. Int. J. Nanomed. 2009, 4, 145. [Google Scholar]
- Klostergaard, J.; Seeney, C.E. Magnetic nanovectors for drug delivery. Nanomed. Nanotechnol. Biol. Med. 2012, 8, S37–S50. [Google Scholar] [CrossRef]
- Saquib, Q.; Al-Khedhairy, A.A.; Ahmad, J.; Siddiqui, M.A.; Dwivedi, S.; Khan, S.T.; Musarrat, J. Zinc ferrite nanoparticles activate IL-1b, NFKB1, CCL21 and NOS2 signaling to induce mitochondrial dependent intrinsic apoptotic pathway in WISH cells. Toxicol. Appl. Pharmacol. 2013, 273, 289–297. [Google Scholar] [CrossRef] [PubMed]
- Vochita, G.; Creanga, D.; Focanici-Ciurlica, E.-L. Magnetic nanoparticle genetic impact on root tip cells of sunflower seedlings. Water Air Soil Pollut. 2012, 223, 2541–2549. [Google Scholar] [CrossRef]
- Gliga, A.R.; Edoff, K.; Caputo, F.; Källman, T.; Blom, H.; Karlsson, H.L.; Ghibelli, L.; Traversa, E.; Ceccatelli, S.; Fadeel, B. Cerium oxide nanoparticles inhibit differentiation of neural stem cells. Sci. Rep. 2017, 7, 1–20. [Google Scholar]
- Atif, M.; Iqbal, S.; Ismail, M.; Mansoor, Q.; Mughal, L.; Aziz, M.H.; Hanif, A.; Farooq, W. Manganese-doped cerium oxide nanocomposite induced photodynamic therapy in MCF-7 cancer cells and antibacterial activity. BioMed Res. Int. 2019, 2019. [Google Scholar] [CrossRef] [PubMed] [Green Version]
- Abbas, F.; Jan, T.; Iqbal, J.; Naqvi, M.S.H.; Ahmad, I. Inhibition of Neuroblastoma cancer cells viability by ferromagnetic Mn doped CeO2 monodisperse nanoparticles mediated through reactive oxygen species. Mater. Chem. Phys. 2016, 173, 146–151. [Google Scholar] [CrossRef]
- Mittal, M.; Gupta, A.; Pandey, O. Role of oxygen vacancies in Ag/Au doped CeO2 nanoparticles for fast photocatalysis. Sol. Energy 2018, 165, 206–216. [Google Scholar] [CrossRef]
- Kusmierek, E. A CeO2 Semiconductor as a Photocatalytic and Photoelectrocatalytic Material for the Remediation of Pollutants in Industrial Wastewater: A Review. Catalysts 2020, 10, 1435. [Google Scholar] [CrossRef]
- Maqbool, Q.; Nazar, M.; Naz, S.; Hussain, T.; Jabeen, N.; Kausar, R.; Anwaar, S.; Abbas, F.; Jan, T. Antimicrobial potential of green synthesized CeO2 nanoparticles from Olea europaea leaf extract. Int. J. Nanomed. 2016, 11, 5015. [Google Scholar] [CrossRef] [PubMed] [Green Version]
- Sundaram, N.; Pahwa, A.K.; Ard, M.D.; Lin, N.; Perkins, E.; Bowles, A.P. Selenium causes growth inhibition and apoptosis in human brain tumor cell lines. J. Neuro-Oncol. 2000, 46, 125–133. [Google Scholar] [CrossRef] [PubMed]
- Venkateswaran, V.; Klotz, L.H.; Fleshner, N.E. Selenium modulation of cell proliferation and cell cycle biomarkers in human prostate carcinoma cell lines. Cancer Res. 2002, 62, 2540–2545. [Google Scholar]
- Storz, P. Reactive oxygen species in tumor progression. Front. Biosci. 2005, 10, 1881–1896. [Google Scholar] [CrossRef] [PubMed] [Green Version]
- Wang, Y.; Yu, X.; Song, H.; Feng, D.; Jiang, Y.; Wu, S.; Geng, J. The STAT-ROS cycle extends IFN-induced cancer cell apoptosis. Int. J. Oncol. 2018, 52, 305–313. [Google Scholar] [CrossRef]
- Hobson-Gutierrez, S.A.; Carmona-Fontaine, C. The metabolic axis of macrophage and immune cell polarization. Dis. Models Mech. 2018, 11, dmm034462. [Google Scholar] [CrossRef] [Green Version]
- Ohmori, Y.; Hamilton, T.A. Interleukin-4/STAT6 represses STAT1 and NF-κB-dependent transcription through distinct mechanisms. J. Biol. Chem. 2000, 275, 38095–38103. [Google Scholar] [CrossRef] [PubMed] [Green Version]
- Kucinski, I.; Dinan, M.; Kolahgar, G.; Piddini, E. Chronic activation of JNK JAK/STAT and oxidative stress signalling causes the loser cell status. Nat. Commun. 2017, 8, 1–13. [Google Scholar] [CrossRef] [Green Version]
- Perillo, B.; Di Donato, M.; Pezone, A.; Di Zazzo, E.; Giovannelli, P.; Galasso, G.; Castoria, G.; Migliaccio, A. ROS in cancer therapy: The bright side of the moon. Exp. Mol. Med. 2020, 52, 192–203. [Google Scholar] [CrossRef] [PubMed]
- Chan, J.S.K.; Tan, M.J.; Sng, M.K.; Teo, Z.; Phua, T.; Choo, C.C.; Liang, L.; Zhu, P.; Tan, N.S. Cancer-associated fibroblasts enact field cancerization by promoting extratumoral oxidative stress. Cell Death Dis. 2018, 8, e2562. [Google Scholar] [CrossRef]
- Toullec, A.; Gerald, D.; Despouy, G.; Bourachot, B.; Cardon, M.; Lefort, S.; Richardson, M.; Rigaill, G.; Parrini, M.C.; Lucchesi, C. Oxidative stress promotes myofibroblast differentiation and tumour spreading. EMBO Mol. Med. 2010, 2, 211–230. [Google Scholar] [CrossRef] [PubMed]
- Son, Y.; Cheong, Y.-K.; Kim, N.-H.; Chung, H.-T.; Kang, D.G.; Pae, H.-O. Mitogen-activated protein kinases and reactive oxygen species: How can ROS activate MAPK pathways? J. Signal Transduct. 2011, 2011. [Google Scholar] [CrossRef]
- Shi, Y.; Nikulenkov, F.; Zawacka-Pankau, J.; Li, H.; Gabdoulline, R.; Xu, J.; Eriksson, S.; Hedström, E.; Issaeva, N.; Kel, A. ROS-dependent activation of JNK converts p53 into an efficient inhibitor of oncogenes leading to robust apoptosis. Cell Death Differ. 2014, 21, 612–623. [Google Scholar] [CrossRef] [Green Version]
- Gibellini, L.; Pinti, M.; Nasi, M.; De Biasi, S.; Roat, E.; Bertoncelli, L.; Cossarizza, A. Interfering with ROS metabolism in cancer cells: The potential role of quercetin. Cancers 2010, 2, 1288–1311. [Google Scholar] [CrossRef] [PubMed] [Green Version]
- Sung, S.-Y.; Kubo, H.; Shigemura, K.; Arnold, R.S.; Logani, S.; Wang, R.; Konaka, H.; Nakagawa, M.; Mousses, S.; Amin, M. Oxidative stress induces ADAM9 protein expression in human prostate cancer cells. Cancer Res. 2006, 66, 9519–9526. [Google Scholar] [CrossRef] [Green Version]
- Gao, Y.; Ma, H.; Qu, G.; Su, L.; Ye, Q.; Jiang, F.; Zhao, B.; Miao, J. A hydrogen sulfide probe activates Nrf2, inhibits cancer cell growth and induces cell apoptosis. RSC Adv. 2017, 7, 42416–42421. [Google Scholar] [CrossRef] [Green Version]
- Kang, K.A.; Piao, M.J.; Hyun, Y.J.; Zhen, A.X.; Cho, S.J.; Ahn, M.J.; Yi, J.M.; Hyun, J.W. Luteolin promotes apoptotic cell death via upregulation of Nrf2 expression by DNA demethylase and the interaction of Nrf2 with p53 in human colon cancer cells. Exp. Mol. Med. 2019, 51, 1–14. [Google Scholar] [CrossRef] [PubMed] [Green Version]
- Moos, P.J.; Chung, K.; Woessner, D.; Honeggar, M.; Cutler, N.S.; Veranth, J.M. ZnO particulate matter requires cell contact for toxicity in human colon cancer cells. Chem. Res. Toxicol. 2010, 23, 733–739. [Google Scholar] [CrossRef] [PubMed]
- Walkey, C.; Das, S.; Seal, S.; Erlichman, J.; Heckman, K.; Ghibelli, L.; Traversa, E.; McGinnis, J.F.; Self, W.T. Catalytic properties and biomedical applications of cerium oxide nanoparticles. Environ. Sci. Nano 2015, 2, 33–53. [Google Scholar] [CrossRef]
- Das, S.; Dowding, J.M.; Klump, K.E.; McGinnis, J.F.; Self, W.; Seal, S. Cerium oxide nanoparticles: Applications and prospects in nanomedicine. Nanomedicine 2013, 8, 1483–1508. [Google Scholar] [CrossRef]
- Pešić, M.; Podolski-Renić, A.; Stojković, S.; Matović, B.; Zmejkoski, D.; Kojić, V.; Bogdanović, G.; Pavićević, A.; Mojović, M.; Savić, A. Anti-cancer effects of cerium oxide nanoparticles and its intracellular redox activity. Chem. Biol. Interact. 2015, 232, 85–93. [Google Scholar] [CrossRef]
- Brenneisen, P.; Reichert, A.S. Nanotherapy and reactive oxygen species (ROS) in cancer: A novel perspective. Antioxidants 2018, 7, 31. [Google Scholar] [CrossRef] [Green Version]
- Colon, J.; Hsieh, N.; Ferguson, A.; Kupelian, P.; Seal, S.; Jenkins, D.W.; Baker, C.H. Cerium oxide nanoparticles protect gastrointestinal epithelium from radiation-induced damage by reduction of reactive oxygen species and upregulation of superoxide dismutase 2. Nanomed. Nanotechnol. Biol. Med. 2010, 6, 698–705. [Google Scholar] [CrossRef]
- Rice, K.M.; Nalabotu, S.K.; Manne, N.D.; Kolli, M.B.; Nandyala, G.; Arvapalli, R.; Ma, J.Y.; Blough, E.R. Exposure to cerium oxide Nanoparticles is associated with activation of Mitogen-activated protein Kinases signaling and apoptosis in rat lungs. J. Prev. Med. Public Health 2015, 48, 132. [Google Scholar] [CrossRef]
- McDonald, J.T.; Kim, K.; Norris, A.J.; Vlashi, E.; Phillips, T.M.; Lagadec, C.; Della Donna, L.; Ratikan, J.; Szelag, H.; Hlatky, L. Ionizing radiation activates the Nrf2 antioxidant response. Cancer Res. 2010, 70, 8886–8895. [Google Scholar] [CrossRef] [Green Version]
- Ritter, B.; Greten, F.R. Modulating inflammation for cancer therapy. J. Exp. Med. 2019, 216, 1234–1243. [Google Scholar] [CrossRef]
- Varga, J.; Greten, F.R. Cell plasticity in epithelial homeostasis and tumorigenesis. Nat. Cell Biol. 2017, 19, 1133–1141. [Google Scholar] [CrossRef]
- Park, S.J.; Kim, H.; Kim, S.H.; Joe, E.-H.; Jou, I. Epigenetic downregulation of STAT6 increases HIF-1α expression via mTOR/S6K/S6, leading to enhanced hypoxic viability of glioma cells. Acta Neuropathol. Commun. 2019, 7, 1–19. [Google Scholar] [CrossRef] [Green Version]
- Brunn, A.; Mihelcic, M.; Carstov, M.; Hummel, L.; Geier, F.; Schmidt, A.; Saupe, L.; Utermöhlen, O.; Deckert, M. IL-10, IL-4, and STAT6 Promote an M2 Milieu Required for Termination of P0106-125-Induced Murine Experimental Autoimmune Neuritis. Am. J. Pathol. 2014, 184, 2627–2640. [Google Scholar] [CrossRef] [PubMed]
- Tewari, R.; Sharma, V.; Koul, N.; Ghosh, A.; Joseph, C.; Sk, U.H.; Sen, E. Ebselen abrogates TNFα induced pro-inflammatory response in glioblastoma. Mol. Oncol. 2009, 3, 77–83. [Google Scholar] [CrossRef] [PubMed]
- Chiang, C.-S.; Fu, S.-Y.; Wang, S.-C.; Yu, C.-F.; Chen, F.-H.; Lin, C.-M.; Hong, J.-H. Irradiation promotes an m2 macrophage phenotype in tumor hypoxia. Front. Oncol. 2012, 2, 89. [Google Scholar] [CrossRef] [Green Version]
- Thabet, N.M.; Moustafa, E.M. Synergistic effect of Ebselen and gamma radiation on breast cancer cells. Int. J. Radiat. Biol. 2017, 93, 784–792. [Google Scholar] [CrossRef]
- Wu, S.; Lu, H.; Bai, Y. Nrf2 in cancers: A double-edged sword. Cancer Med. 2019, 8, 2252–2267. [Google Scholar] [CrossRef] [PubMed]
- Solis, L.M.; Behrens, C.; Dong, W.; Suraokar, M.; Ozburn, N.C.; Moran, C.A.; Corvalan, A.H.; Biswal, S.; Swisher, S.G.; Bekele, B.N. Nrf2 and Keap1 abnormalities in non–small cell lung carcinoma and association with clinicopathologic features. Clin. Cancer Res. 2010, 16, 3743–3753. [Google Scholar] [CrossRef] [PubMed] [Green Version]
- Iizuka, T.; Ishii, Y.; Itoh, K.; Kiwamoto, T.; Kimura, T.; Matsuno, Y.; Morishima, Y.; Hegab, A.E.; Homma, S.; Nomura, A. Nrf2-deficient mice are highly susceptible to cigarette smoke-induced emphysema. Genes Cells 2005, 10, 1113–1125. [Google Scholar] [CrossRef]
- Thimmulappa, R.K.; Lee, H.; Rangasamy, T.; Reddy, S.P.; Yamamoto, M.; Kensler, T.W.; Biswal, S. Nrf2 is a critical regulator of the innate immune response and survival during experimental sepsis. J. Clin. Investig. 2016, 116, 984–995. [Google Scholar] [CrossRef] [PubMed] [Green Version]
- Kondo, Y.; Kanzawa, T.; Sawaya, R.; Kondo, S. The role of autophagy in cancer development and response to therapy. Nat. Rev. Cancer 2005, 5, 726–734. [Google Scholar] [CrossRef] [PubMed]
- Glick, D.; Barth, S.; Macleod, K.F. Autophagy: Cellular and molecular mechanisms. J. Pathol. 2010, 221, 3–12. [Google Scholar] [CrossRef] [PubMed] [Green Version]
- Martinet, W.; De Meyer, G.R. Autophagy in atherosclerosis: A cell survival and death phenomenon with therapeutic potential. Circ. Res. 2009, 104, 304–317. [Google Scholar] [CrossRef] [Green Version]
- Banduseela, V.C.; Chen, Y.-W.; Kultima, H.G.; Norman, H.S.; Aare, S.; Radell, P.; Eriksson, L.I.; Hoffman, E.P.; Larsson, L. Impaired autophagy, chaperone expression, and protein synthesis in response to critical illness interventions in porcine skeletal muscle. Physiol. Genom. 2013, 45, 477–486. [Google Scholar] [CrossRef] [PubMed] [Green Version]
- Katsuragi, Y.; Ichimura, Y.; Komatsu, M. p62/SQSTM 1 functions as a signaling hub and an autophagy adaptor. FEBS J. 2015, 282, 4672–4678. [Google Scholar] [CrossRef] [Green Version]
- Makowska, A.; Eble, M.; Prescher, K.; Hoß, M.; Kontny, U. Chloroquine sensitizes nasopharyngeal carcinoma cells but not nasoepithelial cells to irradiation by blocking autophagy. PLoS ONE 2016, 11, e0166766. [Google Scholar]
- Wang, F.; Tang, J.; Li, P.; Si, S.; Yu, H.; Yang, X.; Tao, J.; Lv, Q.; Gu, M.; Yang, H. Chloroquine enhances the radiosensitivity of bladder cancer cells by inhibiting autophagy and activating apoptosis. Cell. Physiol. Biochem. 2018, 45, 54–66. [Google Scholar] [CrossRef]
- Chaachouay, H.; Ohneseit, P.; Toulany, M.; Kehlbach, R.; Multhoff, G.; Rodemann, H.P. Autophagy contributes to resistance of tumor cells to ionizing radiation. Radiother. Oncol. 2011, 99, 287–292. [Google Scholar] [CrossRef] [PubMed]
- Wang, P.; Zhang, J.; Zhang, L.; Zhu, Z.; Fan, J.; Chen, L.; Zhuang, L.; Luo, J.; Chen, H.; Liu, L. MicroRNA 23b regulates autophagy associated with radioresistance of pancreatic cancer cells. Gastroenterology 2013, 145, 1133–1143.e12. [Google Scholar] [CrossRef] [PubMed]
- Koukourakis, M.I.; Mitrakas, A.G.; Giatromanolaki, A. Therapeutic interactions of autophagy with radiation and temozolomide in glioblastoma: Evidence and issues to resolve. Br. J. Cancer 2016, 114, 485–496. [Google Scholar] [CrossRef]
- Jung, Y.Y.; Lee, Y.K.; Koo, J.S. The potential of Beclin 1 as a therapeutic target for the treatment of breast cancer. Expert Opin. Ther. Targets 2016, 20, 167–178. [Google Scholar] [CrossRef]
- Wu, S.; Sun, C.; Tian, D.; Li, Y.; Gao, X.; He, S.; Li, T. Expression and clinical significances of Beclin1, LC3 and mTOR in colorectal cancer. Int. J. Clin. Exp. Pathol. 2015, 8, 3882. [Google Scholar]
- Chen, Z.; Wang, B.; Yu, F.; Chen, Q.; Tian, Y.; Ma, S.; Liu, X. The roles of mitochondria in radiation-induced autophagic cell death in cervical cancer cells. Tumor Biol. 2016, 37, 4083–4091. [Google Scholar] [CrossRef] [PubMed]
- Ju, L.; Zhao, C.; Ye, K.; Yang, H.; Zhang, J. Expression and clinical implication of Beclin1, HMGB1, p62, survivin, BRCA1 and ERCC1 in epithelial ovarian tumor tissues. Eur. Rev. Med. Pharmacol. Sci 2016, 20, 1993–2003. [Google Scholar] [PubMed]
- Xue, S.; Xiao-Hong, S.; Lin, S.; Jie, B.; Li-Li, W.; Jia-Yao, G.; Shun, S.; Pei-Nan, L.; Mo-Li, W.; Qian, W. Lumbar puncture-administered resveratrol inhibits STAT3 activation, enhancing autophagy and apoptosis in orthotopic rat glioblastomas. Oncotarget 2016, 7, 75790. [Google Scholar] [CrossRef] [PubMed]
- Huang, X.; Qi, Q.; Hua, X.; Li, X.; Zhang, W.; Sun, H.; Li, S.; Wang, X.; Li, B. Beclin 1, an autophagy-related gene, augments apoptosis in U87 glioblastoma cells. Oncol. Rep. 2014, 31, 1761–1767. [Google Scholar] [CrossRef] [Green Version]
- Song, X.; Lee, D.-H.; Dilly, A.-K.; Lee, Y.-S.; Choudry, H.A.; Kwon, Y.T.; Bartlett, D.L.; Lee, Y.J. Crosstalk between apoptosis and autophagy is regulated by the arginylated BiP/Beclin-1/p62 complex. Mol. Cancer Res. 2018, 16, 1077–1091. [Google Scholar] [CrossRef] [Green Version]
- Baek, J.M.; Kim, J.-Y.; Yoon, K.-H.; Oh, J.; Lee, M.S. Ebselen is a potential anti-osteoporosis agent by suppressing receptor activator of nuclear factor kappa-B ligand-induced osteoclast differentiation in vitro and lipopolysaccharide-induced inflammatory bone destruction in vivo. Int. J. Biol. Sci. 2016, 12, 478. [Google Scholar] [CrossRef] [PubMed] [Green Version]
- Vormoor, B.; Schlosser, Y.T.; Blair, H.; Sharma, A.; Wilkinson, S.; Newell, D.R.; Curtin, N. Sensitizing Ewing sarcoma to chemo-and radiotherapy by inhibition of the DNA-repair enzymes DNA protein kinase (DNA-PK) and poly-ADP-ribose polymerase (PARP) 1/2. Oncotarget 2017, 8, 113418. [Google Scholar] [CrossRef] [PubMed] [Green Version]
- Kastan, M.B.; Bartek, J. Cell-cycle checkpoints and cancer. Nature 2004, 432, 316–323. [Google Scholar] [CrossRef] [PubMed]
- Murray, A.W. Recycling the cell cycle: Cyclins revisited. Cell 2004, 116, 221–234. [Google Scholar] [CrossRef] [Green Version]
- Stark, G.R.; Taylor, W.R. Analyzing the G2/M checkpoint. Checkp. Control. Cancer 2004, 280, 51–82. [Google Scholar]
- Li, Y.; Yu, H.; Han, F.; Wang, M.; Luo, Y.; Guo, X. Biochanin A induces S phase arrest and apoptosis in lung cancer cells. BioMed Res. Int. 2018, 2018, 3545376. [Google Scholar] [CrossRef] [PubMed] [Green Version]
- Mariño, G.; Niso-Santano, M.; Baehrecke, E.H.; Kroemer, G. Self-consumption: The interplay of autophagy and apoptosis. Nat. Rev. Mol. Cell Biol. 2014, 15, 81–94. [Google Scholar] [CrossRef] [Green Version]
- Singh, S.S.; Vats, S.; Chia, A.Y.-Q.; Tan, T.Z.; Deng, S.; Ong, M.S.; Arfuso, F.; Yap, C.T.; Goh, B.C.; Sethi, G. Dual role of autophagy in hallmarks of cancer. Oncogene 2018, 37, 1142–1158. [Google Scholar] [CrossRef]
- Aubrey, B.J.; Kelly, G.L.; Janic, A.; Herold, M.J.; Strasser, A. How does p53 induce apoptosis and how does this relate to p53-mediated tumour suppression? Cell Death Differ. 2018, 25, 104–113. [Google Scholar] [CrossRef] [Green Version]
- Adams, J.M.; Cory, S. The BCL-2 arbiters of apoptosis and their growing role as cancer targets. Cell Death Differ. 2018, 25, 27–36. [Google Scholar] [CrossRef] [PubMed] [Green Version]
- Olsson, M.; Zhivotovsky, B. Caspases and cancer. Cell Death Differ. 2011, 18, 1441–1449. [Google Scholar] [CrossRef] [Green Version]
- Lieberthal, W.; Menza, S.A.; Levine, J.S. Graded ATP depletion can cause necrosis or apoptosis of cultured mouse proximal tubular cells. Am. J. Physiol.-Ren. Physiol. 1998, 274, F315–F327. [Google Scholar] [CrossRef] [PubMed]
- Chou, C.C.; Lam, C.Y.; Yung, B.Y.M. Intracellular ATP is required for actinomycin D-induced apoptotic cell death in HeLa cells. Cancer Lett. 1995, 96, 181–187. [Google Scholar] [CrossRef]
- Stefanelli, C.; Bonavita, F.; Stanic, I.; Farruggia, G.; Falcieri, E.; Robuffo, I.; Pignatti, C.; Muscari, C.; Rossoni, C.; Guarnieri, C. ATP depletion inhibits glucocorticoid-induced thymocyte apoptosis. Biochem. J. 1997, 322, 909–917. [Google Scholar] [CrossRef] [PubMed] [Green Version]
- Barrera, G.; Gentile, F.; Pizzimenti, S.; Canuto, R.A.; Daga, M.; Arcaro, A.; Cetrangolo, G.P.; Lepore, A.; Ferretti, C.; Dianzani, C. Mitochondrial dysfunction in cancer and neurodegenerative diseases: Spotlight on fatty acid oxidation and lipoperoxidation products. Antioxidants 2016, 5, 7. [Google Scholar] [CrossRef] [Green Version]
- Liu, D.; Angelova, A.; Liu, J.; Garamus, V.M.; Angelov, B.; Zhang, X.; Li, Y.; Feger, G.; Li, N.; Zou, A. Self-assembly of mitochondria-specific peptide amphiphiles amplifying lung cancer cell death through targeting the VDAC1–hexokinase-II complex. J. Mater. Chem. B 2019, 7, 4706–4716. [Google Scholar] [CrossRef] [PubMed]
- Reheem, A.A.; Atta, A.; Maksoud, M.A. Low energy ion beam induced changes in structural and thermal properties of polycarbonate. Radiat. Phys. Chem. 2016, 127, 269–275. [Google Scholar] [CrossRef]
- Belavi, P.; Chavan, G.; Naik, L.; Somashekar, R.; Kotnala, R. Structural, electrical and magnetic properties of cadmium substituted nickel–copper ferrites. Mater. Chem. Phys. 2012, 132, 138–144. [Google Scholar] [CrossRef] [Green Version]
- El-Shazly, A.N.; El-Sayyad, G.S.; Hegazy, A.H.; Hamza, M.A.; Fathy, R.M.; El Shenawy, E.; Allam, N.K. Superior visible light antimicrobial performance of facet engineered cobalt doped TiO 2 mesocrystals in pathogenic bacterium and fungi. Sci. Rep. 2021, 11, 1–14. [Google Scholar]
- Hu, Y.; Liu, A.; Vaudrey, J.; Vaiciunaite, B.; Moigboi, C.; McTavish, S.M.; Kearns, A.; Coates, A. Combinations of β-lactam or aminoglycoside antibiotics with plectasin are synergistic against methicillin-sensitive and methicillin-resistant Staphylococcus aureus. PLoS ONE 2015, 10, e0117664. [Google Scholar]
- Chandrika, K.M.; Sharma, S. Promising antifungal agents: A minireview. Bioorganic Med. Chem. 2020, 28, 115398. [Google Scholar] [CrossRef] [PubMed]
- Christensen, G.D.; Simpson, W.A.; Bisno, A.L.; Beachey, E.H. Adherence of slime-producing strains of Staphylococcus epidermidis to smooth surfaces. Infect. Immun. 1982, 37, 318–326. [Google Scholar] [CrossRef] [PubMed] [Green Version]
- Maksoud, M.A.; El-Sayyad, G.S.; El-Bastawisy, H.S.; Fathy, R.M. Antibacterial and antibiofilm activities of silver-decorated zinc ferrite nanoparticles synthesized by a gamma irradiation-coupled sol–gel method against some pathogenic bacteria from medical operating room surfaces. RSC Adv. 2021, 11, 28361–28374. [Google Scholar] [CrossRef]
- Agarwal, H.; Nakara, A.; Menon, S.; Shanmugam, V. Eco-friendly synthesis of zinc oxide nanoparticles using Cinnamomum Tamala leaf extract and its promising effect towards the antibacterial activity. J. Drug Deliv. Sci. Technol. 2019, 53, 101212. [Google Scholar] [CrossRef]
- Vichai, V.; Kirtikara, K. Sulforhodamine B colorimetric assay for cytotoxicity screening. Nat. Protoc. 2006, 1, 1112. [Google Scholar] [CrossRef] [PubMed]
- Omar, H.A.; Sargeant, A.M.; Weng, J.-R.; Wang, D.; Kulp, S.K.; Patel, T.; Chen, C.-S. Targeting of the Akt-nuclear factor-κB signaling network by [1-(4-chloro-3-nitrobenzenesulfonyl)-1H-indol-3-yl]-methanol (OSU-A9), a novel indole-3-carbinol derivative, in a mouse model of hepatocellular carcinoma. Mol. Pharmacol. 2009, 76, 957–968. [Google Scholar] [CrossRef] [PubMed] [Green Version]
- Mingone, C.J.; Gupte, S.A.; Quan, S.; Abraham, N.G.; Wolin, M.S. Influence of heme and heme oxygenase-1 transfection of pulmonary microvascular endothelium on oxidant generation and cGMP. Exp. Biol. Med. 2003, 228, 535–539. [Google Scholar] [CrossRef]

| υ1 | υ2 | ||
|---|---|---|---|
| Doped Ferrites | x | cm−1 | cm−1 |
| ZnCexFe2−xO4 | 0.00 | 594.75 | 404.81 |
| 0.02 | 549.12 | 429.17 | |
| 0.04 | 547.97 | 427.66 | |
| 0.06 | 553.24 | 426.81 | |
| 0.08 | 549.99 | 400.32 |
| Pathogenic Microbes | ZOI (mm), ZnCexFe2−xO4 (10 µg/mL) | ZnCexFe2−xO4; X = 0.06 (Starting with 50 µg/mL Concentration) | AX & NS | ||||
|---|---|---|---|---|---|---|---|
| X = 0 | X = 0.02 | X = 0.04 | X = 0.06 | X = 0.08 | |||
| Staphylococcus aureus | Nil | Nil | 9.0 c ± 0.6545 | 13.2 d ± 0.2335 | 10.1 c ± 0.2335 | 0.390 | Nil |
| Pseudomonas aeruginosa | Nil | 7.0 a ± 0.5000 | 9.0 c ± 0.5000 | 9.5 bc ± 0.5000 | 9.5 bc ± 0.555 | 6.250 | Nil |
| Escherichia coli | 7.0 a ± 0.5755 | Nil | 7.0 a ± 1.0000 | 8.5 a ± 0.6545 | 8.0 a ± 0.6545 | 12.50 | Nil |
| Klebsiella pneumoniae | Nil | Nil | Nil | 8.0 a ± 0.5755 | Nil ± 0.6387 | 6.250 | Nil |
| Proteus vulgaris | Nil | Nil | 8.0 b ± 0.5755 | 9.0 b ± 0.2335 | 8.5 ab ± 0.2335 | 12.50 | Nil |
| Salmonella typhi | Nil | Nil | Nil | 9.0 b ± 0.6545 | Nil | 12.50 | Nil |
| Proteus mirabilis | Nil | Nil | Nil | 9.5 c ± 1.0000 | 8.5 b ± 0.2335 | 6.250 | Nil |
| Candida albicans | Nil | Nil | 9.5 d ± 0.6387 | 13.5 d ± 0.5000 | 10.9 c ± 0.2335 | 0.195 | Nil |
| Candida tropicalis | Nil | Nil | Nil | 8.9 ab ± 0.6545 | 8.0 a ± 0.6387 | 12.50 | Nil |
| LSD | --------- | --------- | 0.33330 | 1.00500 | 0.12552 | -------- | ------- |
| Bacterial and Yeast Strains | O.D. of Crystal Violet Stain at 570.0 nm | Inhibition % | |
|---|---|---|---|
| Control | ZnCexFe2−xO4; X = 0.06 (10.0 µg/mL) | ||
| Staphylococcus aureus | 1.058 e ± 0.0080 | 0.020 a ± 0.0021 | 92.73% |
| Pseudomonas aeruginosa | 0.945 d ± 0.0062 | 0.241 c ± 0.0047 | 78.83% |
| Escherichia coli | 0.877 b ± 0.0070 | 0.298 c ± 0.0053 | 75.27% |
| Klebsiella pneumoniae | 0.998 d ± 0.0025 | 0.388 d ± 0.0062 | 61.24% |
| Proteus vulgaris | 0.899 c ± 0.0046 | 0.444 e ± 0.0036 | 56.29% |
| Salmonella typhi | 1.222 f ± 0.0070 | 0.831 a ± 0.0053 | 26.18% |
| Proteus mirabilis | 0.989 d ± 0.0062 | 0.211 c ± 0.0047 | 79.54% |
| Candida albicans | 0.999 d ± 0.0080 | 0.099 b ± 0.0021 | 90.18% |
| Candida tropicalis | 0.557 a ± 0.0080 | 0.451 e ± 0.0021 | 34.16% |
| LSD | 0.01767 | 0.01267 | ------------ |
Publisher’s Note: MDPI stays neutral with regard to jurisdictional claims in published maps and institutional affiliations. |
© 2021 by the authors. Licensee MDPI, Basel, Switzerland. This article is an open access article distributed under the terms and conditions of the Creative Commons Attribution (CC BY) license (https://creativecommons.org/licenses/by/4.0/).
Share and Cite
Abdel-Rafei, M.K.; Thabet, N.M.; Abdel Maksoud, M.I.A.; Abd Elkodous, M.; Kawamura, G.; Matsuda, A.; Ashour, A.H.; El-Batal, A.I.; El-Sayyad, G.S. Influence of Ce3+ Substitution on Antimicrobial and Antibiofilm Properties of ZnCexFe2−xO4 Nanoparticles (X = 0.0, 0.02, 0.04, 0.06, and 0.08) Conjugated with Ebselen and Its Role Subsidised with γ-Radiation in Mitigating Human TNBC and Colorectal Adenocarcinoma Proliferation In Vitro. Int. J. Mol. Sci. 2021, 22, 10171. https://doi.org/10.3390/ijms221810171
Abdel-Rafei MK, Thabet NM, Abdel Maksoud MIA, Abd Elkodous M, Kawamura G, Matsuda A, Ashour AH, El-Batal AI, El-Sayyad GS. Influence of Ce3+ Substitution on Antimicrobial and Antibiofilm Properties of ZnCexFe2−xO4 Nanoparticles (X = 0.0, 0.02, 0.04, 0.06, and 0.08) Conjugated with Ebselen and Its Role Subsidised with γ-Radiation in Mitigating Human TNBC and Colorectal Adenocarcinoma Proliferation In Vitro. International Journal of Molecular Sciences. 2021; 22(18):10171. https://doi.org/10.3390/ijms221810171
Chicago/Turabian StyleAbdel-Rafei, Mohamed K., Noura M. Thabet, M. I. A. Abdel Maksoud, M. Abd Elkodous, Go Kawamura, Atsunori Matsuda, A. H. Ashour, Ahmed I. El-Batal, and Gharieb S. El-Sayyad. 2021. "Influence of Ce3+ Substitution on Antimicrobial and Antibiofilm Properties of ZnCexFe2−xO4 Nanoparticles (X = 0.0, 0.02, 0.04, 0.06, and 0.08) Conjugated with Ebselen and Its Role Subsidised with γ-Radiation in Mitigating Human TNBC and Colorectal Adenocarcinoma Proliferation In Vitro" International Journal of Molecular Sciences 22, no. 18: 10171. https://doi.org/10.3390/ijms221810171
APA StyleAbdel-Rafei, M. K., Thabet, N. M., Abdel Maksoud, M. I. A., Abd Elkodous, M., Kawamura, G., Matsuda, A., Ashour, A. H., El-Batal, A. I., & El-Sayyad, G. S. (2021). Influence of Ce3+ Substitution on Antimicrobial and Antibiofilm Properties of ZnCexFe2−xO4 Nanoparticles (X = 0.0, 0.02, 0.04, 0.06, and 0.08) Conjugated with Ebselen and Its Role Subsidised with γ-Radiation in Mitigating Human TNBC and Colorectal Adenocarcinoma Proliferation In Vitro. International Journal of Molecular Sciences, 22(18), 10171. https://doi.org/10.3390/ijms221810171

